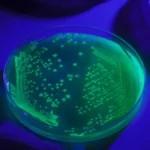

Тёмная материя раскрыла одну из своих тайн
Недавно астрономы сделали важное открытие, наблюдая за впечатляющим столкновением двух скоплений галактик. Это показало наличие темной материи — невидимого вещества, составляющего большую часть Вселенной. Благодаря этому наблюдению мы получили ценные сведения о том, как эта загадочная субстанция взаимодействует с обычной материей, чтобы лучше понять ее роль в структуре нашего космоса.
Понимание темной материи
Темная материя — это форма материи, которая, в отличие от обычной материи, не излучает и не отражает свет. Это делает ее невидимой для наших традиционных приборов обнаружения. Однако о ее присутствии известно благодаря ее гравитационному воздействию на видимые объекты, такие как звезды и галактики. Ученые обнаружили, что темная материя обладает достаточной гравитационной силой, чтобы влиять на формирование и поведение галактик. Без нее галактики рассеивались бы и не образовывали крупные структуры, которые мы наблюдаем сегодня.
Мы также знаем, что темная материя составляет примерно 85 % от общего количества материи во Вселенной и 27 % от ее общей массы-энергии. Однако природа этой загадочной формы материи остается неуловимой. Поэтому любое наблюдение стоит того, чтобы попытаться понять ее.
Впечатляющее галактическое столкновение
Астрономы наблюдали столкновение двух скоплений галактик, получивших название MACS J0018.5+1626. Эти скопления находятся на расстоянии около пяти миллиардов световых лет от Земли. Это означает, что свет от этих скоплений пролетел пять миллиардов лет, прежде чем достиг нас.
Для изучения этого события ученые использовали множество телескопов и обсерваторий. Среди них космические телескопы НАСА «Хаббл» и «Чандра», а также другие приборы, такие как субмиллиметровая обсерватория Калтеха, обсерватория WM Keck и обсерватория Planck. Эти инструменты предоставили важнейшие данные, сделав снимки и измерив излучение света и газа.
Данные собирались в течение нескольких лет и требовали сложного анализа. Астрономы изучили изменения в свете, исходящем от звезд, и поведение горячего газа, чтобы определить, как темная материя движется и взаимодействует во время таких столкновений. Для оценки скорости и направления движения различных типов материи они использовали такие явления, как эффект Суняева-Зельдовича, который измеряет смещения в космическом свете, вызванные движением горячего газа.
Удивительное поведение
Исследователи заметили, что, несмотря на жестокость столкновения между скоплениями галактик, сами отдельные галактики остались относительно целыми. Это явление можно объяснить необъятностью пространства между галактиками, которое достаточно велико, чтобы они не сталкивались напрямую даже при таких космических столкновениях. С другой стороны, образовавшиеся при столкновении обломки, такие как горячий газ и обычная материя, были сильно потревожены ударом. Нагретый до экстремальных температур газ был выброшен и рассеян, а структуры обычной материи деформировались под действием силы столкновения.
Что делает это наблюдение особенно захватывающим, так это поведение темной материи во время столкновения. В отличие от обычной материи, темная материя, похоже, прошла через обломки столкновения практически незатронутой. Такая невидимость в условиях столкновения аналогична тому, как если бы призрак проходил сквозь физические объекты, не взаимодействуя с ними. Это явление крайне важно, поскольку оно демонстрирует, что темная материя не взаимодействует с обычной материей таким же образом. На нее не действуют силы трения и давления, которые влияют на классические частицы, что позволяет ей двигаться независимо от возмущений, вызванных столкновением.
Это открытие открывает новые перспективы для изучения этого вещества. Лучше понимая, как оно ведет себя в экстремальных ситуациях, ученые надеются, что смогут раскрыть больше его загадочных свойств. Эти знания также могут помочь нам понять, как формировались и развивались великие структуры Вселенной, такие как галактики и скопления галактик.
Исследование опубликовано в журнале The Astrophysical Journal.